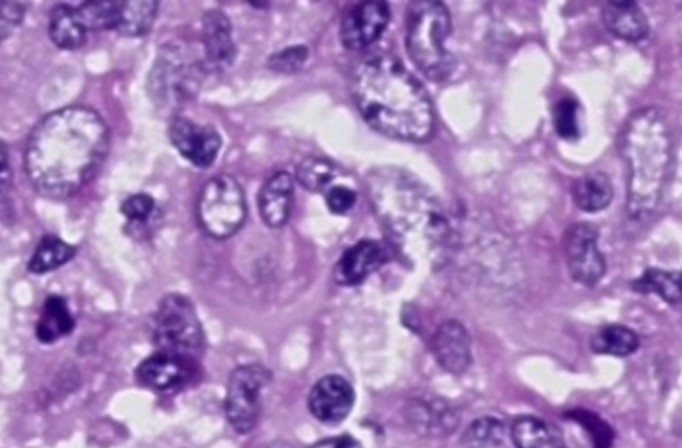
Case 1 Image

President’s Letter
Greetings from the enthusiastic Karnataka Chapter team!
We have had a phenomenal quarter, and our hard work has paid off in multiple ways:
Successful press meetings about WONCA, preconference meet.
Interactions with government officials, including Health Minister Sri Dinesh Gundu Rao, Mr. Harsh Gupta, IAS principal secretary and others, were fruitful as they confirmed their presence at the upcoming WONCA conference.
We hosted a successful WONCA pre-conference physical meet at St. John's, attracting over 140 participants. The theme, "Oncology in Primary Care," sparked engaging discussions. We also felicitated fellowship candidates in Family Medicine, of over 40 talented candidates from across India. This program has achieved remarkable academic success, with over 100 doctors on the waiting list.
Special thanks to Dr. B.C. Rao and Dr. Hema for their vision.
A walkathon with over 500 public participants! The walkathon, themed "Walk for Family Health One Stride at a Time," was a huge success with over 500 public supporting the event organised by TRUSTWELL hospital, supported by dignitaries like Dr. Janavi Nilikini and Rapid Rashmi.
With over 650 registrations and representations from 23 countries, our team's effort has been outstanding @WONCA held at the SHERATON GRAND. Kudos to our state team members and national executive members! for bimodal hybrid conference. It was a stellar show.
The Wonka conference started with a pre-conference workshop on April 4, covering various topics such as:
Emergencies and Urgencies in Primary Care: Discussions focused on managing OPD emergencies
Child Development
Use of AI in Primary Care Research.
The Global Rural Health Summit was a highlight of the conference, attracting international delegates, which included
Dr Bruce Charter
Dr Viviana
Nurse Leaders across globe
Senior Family Medicine Specialists
The summit culminated with the submission of a memorandum to Karnataka's Health Minister, Dinesh Gundu Rao, advocating for the upliftment of primary care and family medicine in the state.
The day ended with a faculty dinner at Bangalore Creative Circus.
Day 2. April 5th had a kickstart with over 650 delegates participating in 4 halls of Sheraton grand. Inaugural ornamented by dance by Bramhari team showcasing the cultural diversity of INDIA, which ended up with a banquet in evening which revelated multifaceted talents of our own practitioners
Chief guest for the 2nd day was shri Dr Gangadhar NMC chairman with keynote address by him on primary care
Day 3 final day witnessed dr Triveni director, MOHFW GOK, Dr Madan immediate principal secretary on health for all discussion with many add-on workshops including difficult IV access.
The Wonka conference was a memorable experience that beautifully blended tradition with innovation, highlighting the evolution and importance of family medicine. It brought together experts, practitioners, and enthusiasts to share knowledge, discuss challenges, and explore new ideas in the field.
The Wonka conference was a testament to the power of family medicine in shaping the future of healthcare.
Dr. Sowmya
President, Karnataka Chapter Team
Dr Sowmya B Ramesh
Dr Sowmya B Ramesh
President, AFPI Karnataka
drsowvivek@gmail.com
Secretary’s Report
Dear Members,
Greetings from the Academy of Family Physicians of India!
It gives me immense pleasure to connect with you through this edition of our quarterly newsletter.
I take this opportunity to extend my heartfelt gratitude to each one of you for your enthusiastic participation in the WONCA South Asia Region Conference 2025, held recently. Your presence and contributions played a pivotal role in making it a grand success and a truly landmark event, with over 650 delegates and representation from 23 countries. The exchange of knowledge, experiences, and ideas at the conference reflected the vibrant spirit and strength of family medicine in our region.
A special word of appreciation to the executive members of the AFPI Karnataka Chapter for their tireless efforts and exemplary coordination that brought this vision to life. I would also like to sincerely thank all members from other state chapters whose support and active involvement significantly enriched the event.
Let us continue to work together to strengthen our discipline and foster professional growth, collaboration, and advocacy for family medicine across the country and beyond.
<
Warm regards,
With warm regards,
Hemavathi D
Dr Hemavathi D,
Hon Gen Secretary, AFPIKA
Editor’s Note
This edition of the newsletter is full of news from the recently concluded WONCA south East Asia conference. It also carries two case reports from a single practice of patients who were infected with multiple drug-resistant serious infections following the holy dip in the recently concluded Kumbh at Prayagraj. Faith is supposed to move mountains but here it is clear that it can kill. When faith replaces common sense, the result is the case reports that you read.
B.C Rao
Badakere.rao@gmail.com
Chief Editor
AFPI Karnataka News

Pic 1:
 Pic 2:
Pic 2:
 Pic 3:
Pic 3:
 Pic 4:
Pic 4:
 Pic 5:
Pic 5:
 Pic 6:
Pic 6:
 Pic 7:
Pic 7:
 Pic 8:
Pic 8:
 Pic 9:
Pic 9:
 Pic 10:
Pic 10:
 Pic 11:
Pic 11:
 Pic 12:
Pic 12:
Wonca SAR
 Pic 13:
Pic 13:
 Pic 14:
Pic 14:
 Pic 15:
Pic 15:
 Pic 16:
Pic 16:
 Pic 17:
Pic 17:
 Pic 18:
Pic 18:
Update
About Non-Steroidal Mineralocorticoid Receptor Antagonists (nsMRAs)
Introduction
Non-steroidal mineralocorticoid receptor antagonists are a type of oral (taken by mouth) prescription medicine used for some people with kidney disease. They are commonly referred to as “nsMRAs”.
There is only one nsMRA available for use in the US – Finerenone (Kerendia). The FDA approved this medicine in 2021. Other nsMRAs are currently being developed and going through clinical trials.
The nsMRAs are considered “kidney protection” medicines – they can help keep glomeruli healthy and lower urine albumin-creatinine ratio (uACR) levels. They can also lower the risk of cardiovascular disease (CVD, including heart failure, heart attack, or stroke).
Uses
Finerenone is only FDA-approved for people with chronic kidney disease and type 2 diabetes. The effects of nsMRAs in people without diabetes are being tested in clinical trials.
How They Work
The nsMRAs work by lowering the effects of aldosterone in the body. Aldosterone helps balance your blood pressure. When your blood pressure starts to go too low, the body makes aldosterone to help bring it up.
The main way aldosterone works is by making kidneys to keep extra sodium (salt) and water in the body. Usually, the kidneys help remove extra sodium and water from the body. When there is too much aldosterone, your kidneys try to keep the extra sodium and water inside your body. This can cause high blood pressure and/or kidney damage. It can also make heart failure worse.
Taking an nsMRA can help lower the amount of extra sodium and water in your body. This will help lower the amount of stress on your kidneys and heart.
The nsMRAs work by lowering the effects of aldosterone in the body.
Effectiveness
In clinical trials, people with chronic kidney disease (CKD) and type 2 diabetes who took an nsMRA (usually added to an ACE inhibitor or ARB) saw many kidney health benefits, including:
- slower progression (worsening) of chronic kidney disease (CKD)
- lower risk of kidney failure
- lower risk of heart attack, stroke, or heart failure exacerbation (flare-up)
- lower uACR level for people with albuminuria
Side Effects
Hyperkalaemia (high potassium levels)
The nsMRAs can raise the level of potassium in your blood. This can cause hyperkalaemia (high potassium levels). Your doctor will likely check your potassium levels before you start this medicine and again a few weeks after. Be sure to complete your blood tests as recommended by your doctor. The nsMRA may need to be stopped or the dose may need to be lowered if your potassium levels go too high.
Low Blood Pressure
The nsMRAs have not been shown in clinical trials to lower blood pressure in most people. Individual results may vary so it is still good to be aware of this possible side effect. Symptoms of low blood pressure include feeling weak, dizzy, or lightheaded. These can be worse when standing up or changing positions. Another symptom of low blood pressure is fatigue (feeling tired). If you have any of these symptoms, talk with your doctor.
Additional Considerations
Importance of Completing Blood Tests
Your doctor will likely need you to complete blood tests to make sure this medicine stays safe for you. This is most important after starting the medicine or after any dose changes. These blood tests include checking your estimated glomerular filtration rate (eGFR) and potassium level. Be sure to complete your blood tests as recommended by your doctor.
Drug Interactions
Grapefruit and grapefruit juice contain an ingredient that can slow the breakdown of Finerenone (an nsMRA) in your body. This can lead to unsafe drug levels in your blood. It is best to avoid eating grapefruit or drinking grapefruit juice while taking Finerenone.
Comparing to Other MRAs
Although the nsMRA class of medicines is new, steroid based MRAs have been available in the US for decades. These include:
- Spironolactone (Aldactone) – commonly used to treat heart failure or high blood pressure. It can also be used to lower uACR levels for people with albuminuria.
- Eplerenone (Inspra) – mainly used to treat heart failure
These medicines are both available as generic options. Compared to the nsMRAs, the steroid based MRAs have a higher risk of causing hyperkalaemia (high potassium levels). This risk is increased even more in people with chronic kidney disease and with lower eGFR levels.
Questions for Your Healthcare Team
- Is nsMRA therapy appropriate for me?
- How often do I need blood tests?
- What symptoms should I watch for?
- Are there any foods or medications I should avoid?
More Resources
- Link to Kidney Health Information
- Link to Clinical Trials on nsMRAs
- FDA Medication Guide for Finerenone
A Case report of Ayuredic medicine induced liver damage
Abstract
Though it is known that ayurvedic [herbal] medicines can cause liver damage, definite evidence is hard to come by. A case report with definite evidence of such damage is reported below.
Introduction
The commonly utilized and over-the-counter available Indian herbs or their extracts, such as Ashwagandha, Aloe vera, Guggul, Puncture vine, Turmeric, Gotu-kola, Bakuchi, Senna, Noni, Malabar tamarind, and Gurmar have been associated with various types of liver injury ranging from acute self-limiting hepatitis, chronic hepatitis, prolonged cholestasis, hepatic sinusoidal obstruction syndrome, cirrhosis, and portal hypertension and can present clinically as acute severe liver injury, acute liver failure, acute decompensation of cirrhosis or acute on chronic liver failure.
Case report 1
Mr Uday Unni, A 54-year-old gentleman, reported on 10/12/24 with Pain in the left knee joint of a few months’ duration. He is on long term medication with 200mgs of Allopurinol for Gout. On examination he had normal blood pressure and pulse and all the vitals were normal except presence of / icterus. Locally the joint was normal with full movements and no pain, swelling or fluid collection. In view of the icterus a repeat history taking revealed that he was on Ayuredic drugs for the past 8 months for the knee pain which he felt was better but not fully gone.
He was asked to get back with hemogram, Liver and kidney function tests. He reported back on 13/12/24 with the following reports.
LFT
Bilirubin 3.53
SGOT 524
SGPT 735
GGT 325
Creatinine 1.32
He was asked to stop all Ayurvedic drugs [see the photos above] and get back after 6 weeks or earlier if there are any worsening symptoms.
He returned on 3/1/25 and following are his reports
Follow-up LFT
Bilirubin 0.49
SGOT 50.14
SGPT 36.94
GGT 179.36
Creatinine 1.32
As one can see, his liver recovered within a matter of six weeks after stopping the drugs. He was fortunate that the injury was not permanent.
 Pic 19:
Pic 19: Pic 20
Pic 20Conclusion
A case of herbal drug induced liver injury which was reversed on stopping the drugs is reported.
References
Vol. 8. Issue 3. Annals of hepatology
Pages 258-266 (July - September 2009)
Severe hepatotoxicity by Indian Ayurvedic herbal products: A structured causality assessment,
Rolf Teschke Ruediger Bahre**
Department of Internal Medicine II, lecturer at the University of Frankfurt/Main and professor at the University of Duesseldorf, Germany.
World J Hepatology
2020 Sep 27;12(9):574–595. doi: 10.4254/wjh.v12.i9.574
Cyriac Abby Philips 1, Rizwan Ahamed 2, Sasidharan Rajesh 3, Tom George 4, Meera Mohanan 5, Philip Augustine 6
Case report 2
Patient No 1
Mr. S, a 26-year-old male, attended the Kumbh Mela on January 13th and 14th, during the earlier part of the festival, where he participated in ritual bathing. He returned to Mysore after two days. On January 21st (seven days post-exposure), he developed fever accompanied by chills, rigors, and severe body pain. There was no history of cough, cold, or diarrhoea.
Following investigations were done after admitting him on2/2/25
Hemogram Relative leucocytosis.
LFT ALT115, SGPT 110, SGOT 84, CRP44 AND ESR75.
Urine analysis normal
Procalcitonin 1.41
Weil Felix Negative
US Abdomen Bilateral renal calculi. Nonspecific thickening of caecal wall [Typhlitis]
X-ray chest Normal
Blood culture Klebsiella Aerogenes
Treated with Meropenem, Magnus forte, Doxycycline, Inj Amikacin.
He became fever free and was discharged on 10/2/25 with advised to continue Amikacin and meropenem on an OPD basis for five days more.
Subsequently, he travelled to Bangalore. Fifteen days later, he experienced a recurrence of high fever with severe chills, rigors, body pain, and loss of appetite, predominantly in the evenings and nights. He had no additional symptoms or signs, except for high fever with rigors.
Routine blood tests, along with blood and urine cultures, were performed.
Blood culture identified Salmonella Typhi, sensitive to ceftriaxone, and urine culture showed Enterococcus faecium, sensitive only to linezolid. The patient was treated with intravenous ceftriaxone 2 grams daily for ten days and oral linezolid 600 mg twice daily for ten days. He became afebrile after five days. Subsequently, he received the conjugated typhoid vaccine and is currently well.
Patient no 2
Mr. T, a 68-year-old male with known diabetes mellitus, hypertension, and chronic kidney disease (serum creatinine: 1.8 mg/dL), visited the Kumbh Mela on February 20th, during the latter half of the festival, and participated in ritual bathing. Fifteen days later, he developed severe chills, rigors, high fever, severe body pain, and a mild cough, with no other significant signs. He appeared ill, with a fever of 102°F and tachycardia.
Considering his comorbid conditions, immediate investigations were ordered, and empirical treatment with oral ceftriaxone 500 mg twice daily and azithromycin 500 mg once daily was initiated.
Laboratory results showed a white blood cell count of 23,000/cu.mm with 89.8% neutrophils, and serum sodium of 126 mEq/L. Blood cultures grew Streptococcus pneumoniae, and urine cultures grew Escherichia coli. As the initial antibiotics were appropriate based on sensitivity results and the patient showed improvement after three days, the treatment was continued for ten days. The patient has since returned to his baseline health.
Details of Laboratory Investigation:
Please find in attachments:
Discussion
These two cases highlight the potential risk of infections following participation in large gatherings such as the Kumbh Mela, which attracts millions of people. The different incubation periods of various pathogens can lead to staggered onset of illnesses, and individuals may acquire multiple infections over time. Clinicians, especially primary care physicians who are often the first point of contact, should maintain a high index of suspicion and adopt a scientific approach when evaluating patients with recent exposure to mass gatherings.
Dr H S Mruthyunjaya
Case report 3
Mr S, an 85-year-old retired air force officer, was advised by his dentist to see me as she found his gums enlarged. Except for gum hypertrophy, his mouth and teeth were normal. Drug history revealed that he was on amlodipine for several years, and this drug had kept his BP under excellent control. As the hypertrophy was not causing him any distress after discussing with him, it was decided to wait and watch for a couple of more months and then take a call.
Literature search revealed that Amlodipine does cause gum hypertrophy, but it is a rare side effect. The drugs which commonly cause gum hypertrophy are the anticonvulsants.
 Pic 21: Gum hypertrophy
Pic 21: Gum hypertrophy Pic 22: Gum hypertrophy
Pic 22: Gum hypertrophy
Practice Experience
Glucosamine Induced Hyperglycemia in a Diabetic
A seventy-year-old gentleman, well-controlled diabetic and hypertensive, reported impaired control since a month despite being on the same diet and activity schedule. On checking, it was found that he had been prescribed Cartigen (one of the many brands of Glucosamine).
This drug of dubious value is prescribed extensively, particularly by orthopedicians for osteoarthritis. It is also a favourite supplement recommended by gym trainers and physiotherapists. This supplement is also given for extended periods. Glucosamine is known to increase blood sugars.
This patient was asked to stop this supplement, and his sugars came under control within two weeks’ time.
Interesting Information
Two days ago, a person from Tripura was referred by a dentist for a genetic opinion. He was 40 years old and had persistent hyperglycaemia. Fasting sugar was 220, and post-prandial sugar 370. Surprisingly, his HbA1c was 3.5 and was rechecked in three reputed labs. The dentist was in a dilemma as he had planned for an oral surgery for that patient.
Immediately, I arranged for an electrophoresis of his haemoglobin, and the pattern came as Hb E. Routine HbA1c can measure only when the person has normal HbA. In HbE haemoglobinopathy, there will be very little HbA, and so HbA1c measurement was deceptively low.
In Northeast India, Hb E disease is present in 20% of the population. Malaria was rampant in Northeast India, and the HbE gene gave some protection against malaria, and so this gene flourished, though this gene itself is harmful. But it protected people from deaths due to malaria. Now malaria is dwindling and so the HbA gene has again started increasing.
Clinical Recommendation
Hence, in a diabetic patient, if the HbA1c is persistently low despite persistent hyperglycaemia, always order for a haemoglobin electrophoresis to detect any underlying haemoglobinopathy.
[This was received as a forward by the editor and was authenticated by a haematologist]
Stroke Prevention in Atrial Fibrillation
Stroke is the 2nd leading cause of death in the world. Its incidence is 100 – 150 per 100,000 people per year, and is rising in Low and Middle-income countries. Apart from being a leading cause of disability, it carries a high mortality as well – 15%, 40%, 50%, and 75% at 1 month, 1, 2 and 5 years respectively. Atrial Fibrillation is a leading preventable cause of ischemic stroke and causes up to 20% of them. Effective anti-coagulation can prevent up to 70% of strokes due to AF.
 Pic 23: How stroke occurs in atrial fibrillation
Pic 23: How stroke occurs in atrial fibrillation
Over the years, 3 categories of drugs have been used to prevent strokes in AF.
1. Antiplatelet drugs – Aspirin and Clopidogrel.
2. Anti-coagulants – Vitamin K antagonists – Warfarin and Acitrom.
3. DOACS – Direct oral anti-coagulants or NOACS – Newer ( Novel ) oral anti-coagulants - Dabigatran, Rivaroxaban, & Apixaban.
The availability of the 3rd category of drugs over the last decade has radically transformed therapy, because of ease of use, lack of need for monitoring with tests like Prothrombin Time (PT), greater efficacy and greater time in therapeutic range.
Elaborate scoring systems have evolved to ascertain an individual’s risk of ischemic stroke due to AF, as well as his/her risk of bleeding. However, as these may be a bit too complicated for routine use in clinical practice, the thumb rule is as follows:
An elderly patient in AF who has no history of Hypertension, Diabetes, Congestive heart failure, Myocardial infarction or stroke does NOT need prophylactic anticoagulation.
An elderly patient in AF, who has one or more of the above risk factors, needs oral anti-coagulation with one of the NOACS, unless his/her risk of bleeding is prohibitively high.
1. Systolic BP over 160 mm Hg.
2. Chronic Kidney Disease – Creatinine over 2.26 mg/dl.
3. Chronic liver disease – AST/ALT over 3 times the upper limit of normal.
4. Prior major bleed or predisposition to bleed.
5. Concurrent need for antiplatelet drugs such as H/o MI, PTCA, CABG.
6. Alcohol usage over 8 units per week.
If 3 or more of these risk factors are present, the risk of bleeding will neutralise the protective effects of NOACS, and they are best avoided.
However, in a given patient, the risk of ischemic stroke versus bleeding needs to be evaluated, and therapy individualised using these guidelines.
Dr Padmakumar
Not every swollen gland has TB’s hand; a case series
Dr Udata Pranavi, Dr Ramya S; Department of Family Medicine, SJMCH.
Case 1
Patient: 28/F, homemaker from Bangalore, Karnataka
History:
- Painless swelling in the right side of neck - 3 weeks
- High-grade, intermittent fever - 3 weeks
- Multiple small & large joint painful swelling - 3 weeks
Examination: Pallor+, left submandibular LN+ (multiple, matted, mobile, smooth surface, 3x5 cm), right supraclavicular LN (single, mobile, smooth, 2x2 cm), B/L pitting pedal oedema. Systems: Normal. MSK: tender, warm swellings of small & large joints with painful range of movements.
Investigations: Hb: 9.8, TLC (DC): 1.92 (56/37/0.5/6.1/0), ESR: 44 mm/hr, RF, Anti-CCP: <10,7, USG neck: Multiple enlarged LN (Ib, II-V) bilateral with loss of fatty hilum, FNAC: Histiocytes aggregates with scanty necrosis, Biopsy: Histiocytosis with scanty necrosis.
Diagnosis: Kikuchi disease
Treatment: T. Indomethacin 25mg BD for 2 weeks
Case 2
Patient: 44/F, homemaker from Kudappa, Andhra Pradesh
History:
- Significant unintentional weight loss - 3 months
- High-grade, intermittent fever - 2 days
- Painless swelling on the left side of neck - 2 days
- Past history of 6 months ATT due to clinical TB lymphadenopathy
Examination: Pallor+, single right upper jugular LN (smooth, mobile, nontender, 1x1.5cm), single left lower jugular LN (smooth, mobile, nontender, 1x1cm), fine tremor of hand+. Systems: Normal.
Investigations: Hb: 9.9, TLC (DC): 5.43 (62.1/20.4/0.9/16.4/0.2), ESR: 37 mm/hr, TSH / FT4 / FT3: 0.00002/4.08/17.1, FNAC: florid reactive hyperplasia with immunoblastic response, T99 thyroid scan: diffuse toxic goitre.

Diagnosis: Graves disease
Treatment: T. Carbimazole 20mg OD, T. Propranolol 20mg BD
Case 3
Patient: 66/M, farmer from Hosur, Tamil Nadu
History:
- Reduced appetite – 6 months
- Significant unintentional weight loss – 2 months
- Low-grade, intermittent fever with chills and myalgia – 2 weeks
Examination: Pallor+, multiple b/l submandibular and upper jugular LN (mobile, smooth, not matted, non-tender, largest 4x5 cm), b/l axillary LN (mobile, smooth, not matted, non-tender, largest 1x2 cm). Systems: Normal.
Investigations: Hb: 13, TLC (DC): 7.02 (64.3/31.9/0/3.4/0.4), PC: 61000, ESR: 45 mm/hr, AST/ALT: 685/444, ALP/GGT: 629/265, Ab to OX K: 1:80 titres, USG neck & axilla: B/L multiple non-matted cervical and axillary LN with loss of fatty hilum, FNAC (axillary LN): Monomorphic lymphoid cell hyperplasia.

Diagnosis: Rickettsial fever
Treatment: T. Doxycycline 100mg BD for 2 weeks
Case 4
Patient: 45/F, homemaker from Attibele, Karnataka
History:
- High-grade intermittent evening fevers with chills - 10 days
- Frontal dull aching headache - 10 days
- Progressive shortness of breath with no orthopnea - 8 days
Examination: Pallor+, multiple B/L cervical & inguinal LN (mobile, smooth, not matted, non-tender, largest 3x3 cm in right inguinal area). Systems: Normal.
Investigations: Hb: 10.4, TLC (DC): 9.22 (50.6/44.9/0.1/4.0/0.4), ECG/ECHO: NSR/EF-58%, CXR: Mild B/L pleural effusion, Ab to OX K: 1:80 titres, Scrub IgM: positive, FNAC (right inguinal LN): Atypical lymphoid cells, lymphoproliferative disease.

Diagnosis: Rickettsial fever
Treatment: T. Doxycycline 100mg BD for 2 weeks
Conclusion
>Microbiological/pathological evidence for tuberculosis as mandated cannot be broken. Hence, other differentials also have to be sought even in the presence of constitutional symptoms of tuberculosis and in the absence of laboratory evidence.
Below is the link to access to all the deliberations and extracts to the just concluded Wonca south east Asia conference